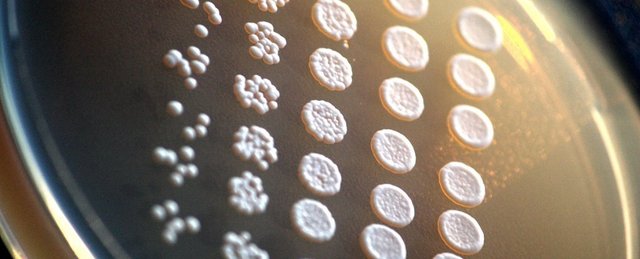
featured

RickJS (44)
Latin Entrepreneur, UI/UX Designer, Computer Sciences Engineer
127 followers36 posts77 following0 HP
Blacklisted UsersMuted UsersFollowed BlacklistsFollowed Muted Lists
Blacklisted UsersMuted UsersFollowed BlacklistsFollowed Muted Lists
Venezuela Joined January 2018 Active 8 years ago